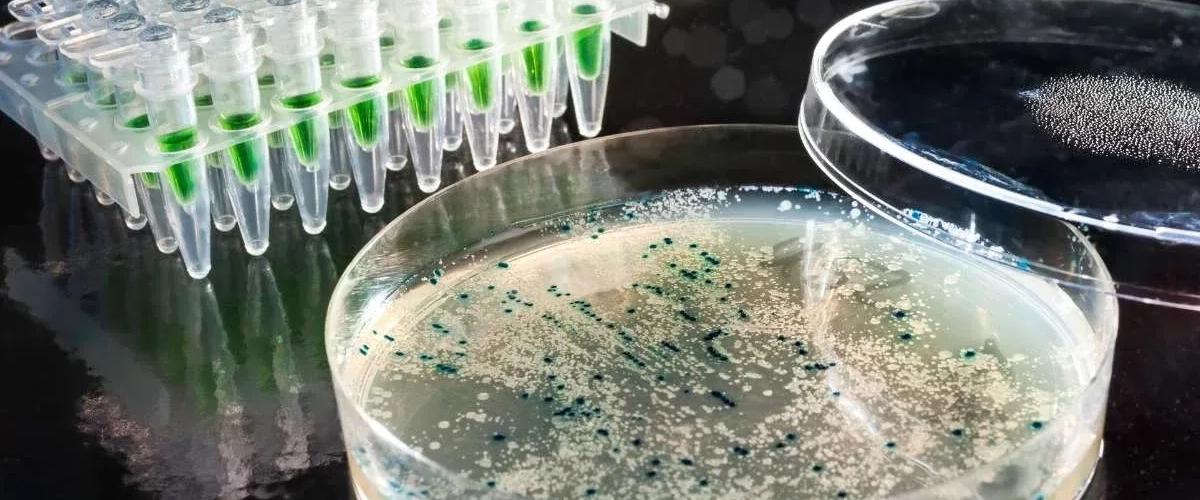
TODO:

Для разработки фотоактивного антибиотика ученые начали с молекулы, полученной из природного соединения кумарина. Они химически связали ее с компонентом антибиотика пенициллина, который убивает бактерии через разрушение их клеточных стенок. В результате пока молекула кумарина связана с препаратом, антибиотик остается неактивным, сообщается на сайте Американского химического общества.
Отделение антибиотика возможно только с помощью воздействия зеленого света. Когда сигнал получен, препарат активируется и уничтожает патоген в месте воздействия. По замыслу авторов, свет можно проецировать наружно локально или доставлять с помощью эндоскопа в зависимости от типа инфекции.
Первые доклинические эксперименты показали эффективность новой технологии против кишечной палочки и золотистого стафилококка. Теперь ученые хотят расширить систему до нескольких лучей различных цветов, чтобы обеспечить еще больший контроль, а также точечное уничтожение бактерий в более крупных моделях животных. Если результаты окажутся успешными, то новая технология позволит значительно снизить риски развития резистентности бактерий — серьезную проблему современной системы здравоохранения, связанную с высоким уровнем смертности.
Еще один способ профилактики резистентности ранее представили ученые из Пенсильванского университета. Они показали, что уже доступный препарат может связывать нецелевые антибиотики и выводить их из организма.